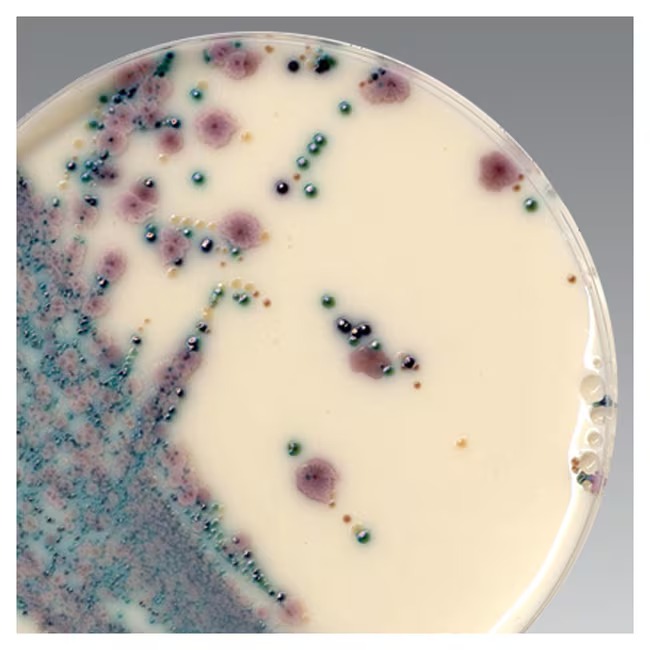
Thermo Scientific™ Brilliance™ Candida Selective Supplement, 10 x 10 mL
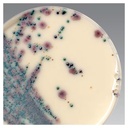
Thermo Scientific™ Brilliance™ Candida Selective Supplement, 10 x 10 mL

Thermo Scientific™ Brilliance™ Candida Selective Supplement, 10 x 10 mL
Catalog No :
CAS Number :
Brand :
In Stock
Specifications:
| Application | Microbiology | ||
| Storage Temperature | 2-8°C | ||
| Product Type | Supplement | Forms | Lyophilized |
| Product Brand | Thermo Fisher Scientific™, Oxoid | ||
| Product Grade | Microbiology grade | ||
The Thermo Scientific™ Brilliance™ Candida Selective Supplement is a freeze-dried additive designed to enhance the selectivity of Brilliance™ Candida Agar Base (CM1002A & CM1002B). It is specifically formulated to suppress competing microbial flora while supporting the optimal growth, isolation, and differentiation of clinically important Candida species.
When used in combination with the chromogenic agar base, this supplement ensures improved recovery and clearer differentiation of target yeasts from mixed clinical samples, making it an essential component for accurate fungal diagnostics.
Key Features & Benefits
-
Enhanced Selectivity
Inhibits bacterial contaminants and non-target organisms, improving Candida isolation from polymicrobial samples. -
Optimized Performance with Brilliance™ Agar Base
Designed specifically for use with Brilliance™ Candida Agar Base (CM1002A/CM1002B) to achieve full chromogenic differentiation. -
Improved Diagnostic Accuracy
Reduces background interference, enabling clearer colony color development and easier interpretation. -
Convenient Freeze-Dried Format
Ensures long shelf life, stability, and ease of preparation. -
Consistent & Reliable Results
Each vial delivers standardized supplementation for reproducible performance across batches.
Applications
- Clinical microbiology laboratories
- Hospital diagnostic laboratories
- Isolation of Candida spp. from oral and genital specimens
- Processing of mixed microbial samples
- Routine fungal screening and diagnostics
Technical Specifications
| Parameter | Specification |
|---|---|
| Product Name | Brilliance™ Candida Selective Supplement |
| Catalog Number | SR0231E |
| Format | Freeze-dried (lyophilized) |
| Pack Size | 10 vials per pack |
| Yield | Each vial supplements 500 mL of medium |
| Product Type | Selective Supplement |
| Compatible Media | Brilliance™ Candida Agar Base (CM1002A, CM1002B) |
| Application | Isolation & differentiation of Candida spp. |
Usage Information
- Reconstitute each vial as per manufacturer instructions
- Add to 500 mL of prepared Brilliance™ Candida Agar Base
- Mix thoroughly before pouring plates
- Use immediately after preparation for optimal performance
Unique Advantages
- Essential companion product for Brilliance™ Candida Agar system
- Enhances clarity of chromogenic reactions
- Improves recovery of clinically significant yeasts
- Supports faster and more reliable diagnosis
- Minimizes contamination-related false interpretations
The Thermo Scientific™ Brilliance™ Candida Selective Supplement is a critical component for laboratories using chromogenic media for Candida detection. By enhancing selectivity and improving clarity of results, it ensures accurate, efficient, and reliable fungal identification in clinical diagnostics.




 0
0